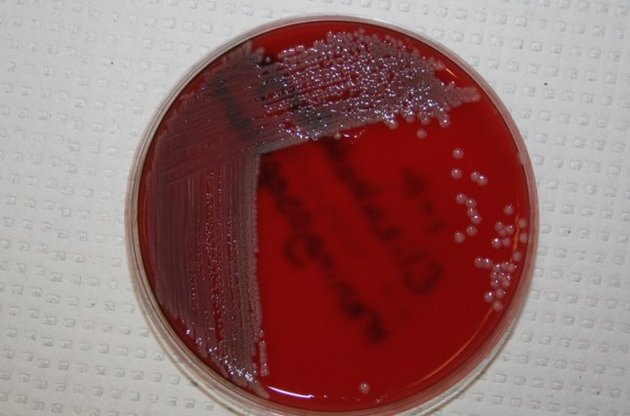
Мичиган &ndash; это уже второй американский штат, где зарегистрирована смерть от этой инфекции

Специалисты департамента здравоохранения штата Мичиган подтвердили факт смерти 18 человек после заражения неизвестной кровяной инфекцией. Общее количество зараженных достигает 50 человек, пишет издание The Washington Post.
Мичиган – это уже второй американский штат, где зарегистрирована смерть от неизвестного ранее заболевания.
Чуть ранее вспышка инфекции была зафиксирована в Висконсине, где неизвестная инфекция стала причиной смерти 17 человек.
Известно, что бактерии Elizabethkingia распространяются в воде и почве, но не вызывают заражения организма. Они также не передаются при контакте с инфицированным человеком. Некоторые специалисты считают, что инфекция могла поразить пациентов через медоборудование, например, через трубки для кормления или зонды.
Ранее сообщалось о другом опастном заболевании, которое в последнее время широко распростронилось. Так, ВОЗ объявила вирус Зика глобальной угрозой. В ВОЗ прогнозируют, что в 2016 году вирусом могут заразиться до 4 миллионов человек в Южной и Северной Америке. На данный момент случаи заболевания отмечены в 22 странах мира.
Вакцины для предотвращения инфицирования вирусом Зика или ее лечения не существует. Разносчиком вируса является комар Aedes aegypti. Вирус Зика является крайне опасным для организма в период внутриутробного развития. В Бразилии уже выявлено 3893 случая микроцефалии, предположительно вызванной данной болезнью. Согласно информации ВОЗ, на данный момент в стране инфицированы около 1,5 млн человек.